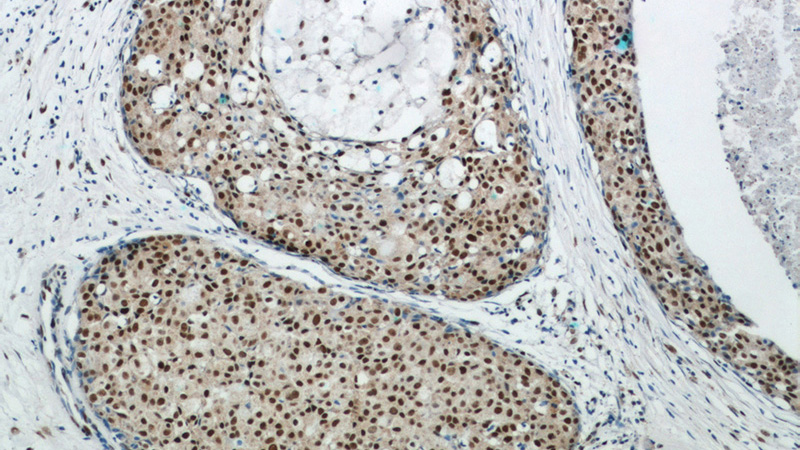
Immunohistochemical of paraffin-embedded human breast cancer using Catalog No:110804(GABPA antibody) at dilution of 1:50 (under 10x lens)
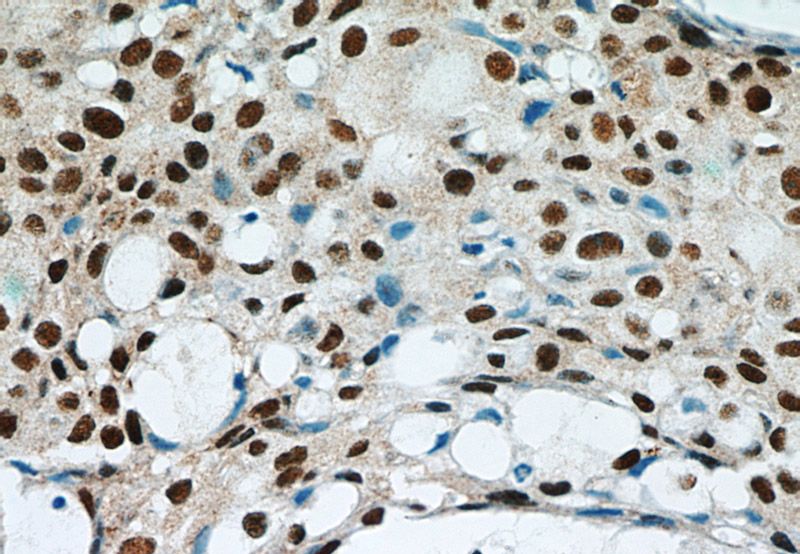
Immunohistochemical of paraffin-embedded human breast cancer using Catalog No:110804(GABPA antibody) at dilution of 1:50 (under 40x lens)

-
Product Name
GABPA antibody
- Documents
-
Description
GABPA Rabbit Polyclonal antibody. Positive IHC detected in human breast cancer tissue, human cervical cancer tissue. Positive IP detected in HeLa cells. Positive WB detected in K-562 cells, A431 cells, A549 cells, HEK-293 cells, HT-1080 cells, MCF7 cells, mouse liver tissue, NIH/3T3 cells, rat brain tissue. Observed molecular weight by Western-blot: 56-60 kDa
-
Tested applications
ELISA, WB, IHC, IP
-
Species reactivity
Human, Mouse, Rat; other species not tested.
-
Alternative names
E4TF1 60 antibody; E4TF1A antibody; GA binding protein alpha chain antibody; GABP subunit alpha antibody; GABPA antibody; NFT2 antibody; Transcription factor E4TF1 60 antibody
-
Isotype
Rabbit IgG
-
Preparation
This antibody was obtained by immunization of GABPA recombinant protein (Accession Number: XM_047440739). Purification method: Antigen affinity purified.
-
Clonality
Polyclonal
-
Formulation
PBS with 0.02% sodium azide and 50% glycerol pH 7.3.
-
Storage instructions
Store at -20℃. DO NOT ALIQUOT
-
Applications
Recommended Dilution:
WB: 1:500-1:5000
IP: 1:500-1:5000
IHC: 1:20-1:200
-
Validations

K-562 cells were subjected to SDS PAGE followed by western blot with Catalog No:110804(GABPA antibody) at dilution of 1:1000
Immunohistochemical of paraffin-embedded human breast cancer using Catalog No:110804(GABPA antibody) at dilution of 1:50 (under 10x lens)
Immunohistochemical of paraffin-embedded human breast cancer using Catalog No:110804(GABPA antibody) at dilution of 1:50 (under 40x lens)

IP Result of anti-GABPA (IP:Catalog No:110804, 4ug; Detection:Catalog No:110804 1:1000) with HeLa cells lysate 1200ug.
-
Background
GA-binding protein alpha chain (GABP alpha subunit, GABPA, nuclear respiratory factor 2 subunit alpha, transcription factor E4TF1-60) is one of three GA-binding protein transcription factor subunits which functions as a DNA-binding subunit.GABPA is a member of Ets family, binds to the Yap promoter and activates YAP transcription(23684612). Since this subunit shares identity with a subunit encoding the nuclear respiratory factor 2 gene, it is likely involved in activation of cytochrome oxidase expression and nuclear control of mitochondrial function. This subunit also shares identity with a subunit constituting the transcription factor E4TF1, responsible for expression of the adenovirus E4 gene. Because of its chromosomal localization and ability to form heterodimers with other polypeptides, this gene may play a role in the Down Syndrome phenotype.
-
References
- Wu H, Xiao Y, Zhang S. The Ets transcription factor GABP is a component of the hippo pathway essential for growth and antioxidant defense. Cell reports. 3(5):1663-77. 2013.
- Dworatzek E, Mahmoodzadeh S, Schubert C. Sex differences in exercise-induced physiological myocardial hypertrophy are modulated by oestrogen receptor beta. Cardiovascular research. 102(3):418-28. 2014.
Related Products / Services
Please note: All products are "FOR RESEARCH USE ONLY AND ARE NOT INTENDED FOR DIAGNOSTIC OR THERAPEUTIC USE"
